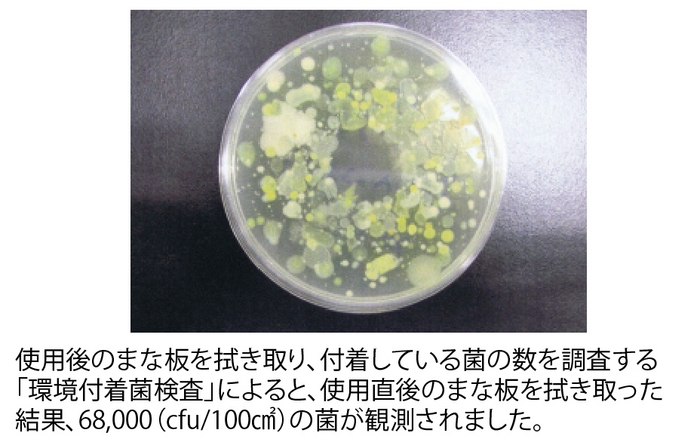
使用直後のまな板をふき取った結果
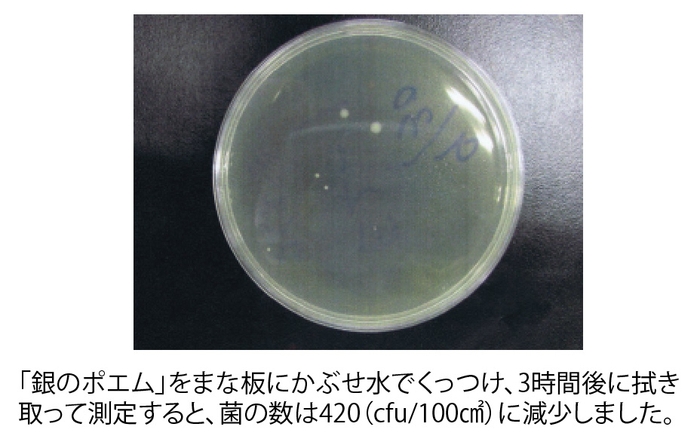
「銀のポエム」をかぶせると菌の数が減少

恵比寿のバー「PAO」がWイオン効果のマスクを開発して限定販売 外飲みにも!除菌消臭、敏感肌ケアの生地使用
銀イオン&マイナスイオンを繊維化! ~クラフトジン/パン・ビオワインのバー「PAO」~
クラフトジン/パン・ビオワインのバー「PAO」(東京都渋谷区恵比寿)は、外飲みでの感染拡大を防ぐと共に身に着けることで除菌、消臭、うるおい肌効果、水洗いで清潔を保ちやすい『PAOマスク』を開発し、「BASE」ネットショップおよび店内にて販売を開始しました。

PAO BASEショップ: https://pao287.theshop.jp/
PAOマスクの特徴
PAOマスクは3層構造。1枚目と3枚目に敏感肌ケア効果のある「IOCA-C21(R)」を、その間の2枚目にはウイルス増殖を抑制する銀糸を編み込んだ繊維「銀のポエム」という2種類の生地を組み合わせています。
素材にこだわり熱い夏に臭いを気にすることなく肌荒れの心配もないマスク、外飲みに出かける際、様々なファッションスタイルに合わせやすいナチュラルな色のマスクとなっています。
2020年4月から開発テストをしながら国内製素材、国内縫製にこだわった500枚限定生産(M、Lサイズ合計)になります。

2種類の生地特徴
(1) 銀のポエム
開発:オーガンジー繊維製造 株式会社コイズミ(所在地:石川県かほく市)
http://koizumi-co.jp/product/poem/
銀糸のチカラがウイルスの増殖を抑制!抗菌効果で、食中毒に備える静菌活性値5.5が示す驚きの抗菌防臭効果。※一般社団法人繊維評価技術協議会が定める繊維製品の抗菌性試験方法及び抗菌効果に基づく性能評価による
中世ヨーロッパでは、銀の食器が使われていたように、銀が持つ抗菌の作用は古くから伝えられてきました。銀の糸に含まれるイオンがウイルスの増殖を阻止する力を活かして、「銀のポエム」は誕生しました。織物メーカーの高い技術力で、銀の糸を編みこむことに成功、抗菌効果を持つ商品が実現しました。
「環境付着菌検査」によると、使用直後のまな板を拭き取った結果、68,000(cfu/100cm2)の菌が観測されました。「銀のポエム」をまな板にかぶせ水でくっつけ、3時間後に拭き取って測定すると、菌の数は420(cfu/100cm2)に減少しました。(検査実施機関:厚生労働大臣登録検査機関 株式会社アルプ)
(2) IOCA-C21(イオカ)ファブリック
開発:オーガンジー繊維製造 株式会社コイズミ(所在地:石川県かほく市)
IOCA-C21(R)はマイナスイオンを発生し、ホルミシス効果を示す良質のマイナスイオン粒子と、遠赤外線を発生しジアテルミー効果をもつ炭素粒子の両者をナノテクノロジーを駆使して繊維化したものです。ナノテクノロジーを駆使した繊維は、体細胞に直接作用します。
ホルミシス(マイナスイオン)機能
細胞機能の活性化、新陳代謝機能の促進作用により、体内で崩れたイオンバランスを整えます。
IOCA-C21(R)は医化学的繊維として各種バックデータもあり、信頼性の高い機能素材です。
※尚、IOCA-C21(R)の有する生体への機能性は「第32回日本臨床免疫学会総会」及び「第18回日本バイオセラピィ学会学術集会総会」に於いて発表されました。
商品概要
商品名 :PAOマスク
価格 :1枚1,600円(送料別)
サイズ :M/L(合計500枚限定)
販売場所:PAO BASE ショップ https://pao287.theshop.jp/
PAO 店舗内 https://www.facebook.com/infopao287/
クラフトジン/パン・ビオワインのバー「PAO」店舗概要
所在地 : 〒150-0013 東京都 渋谷区恵比寿2-8-7
営業形態: 日-火-水曜日…クラフトジン・バー
木-金-土曜日…パン(※)とビオワイン・バー
定休日 : 月曜
Facebook: https://www.facebook.com/infopao287/
(※)「丘の上のパン」(所在地:横浜市青葉区、設計:株式会社スーパープランナーズ)